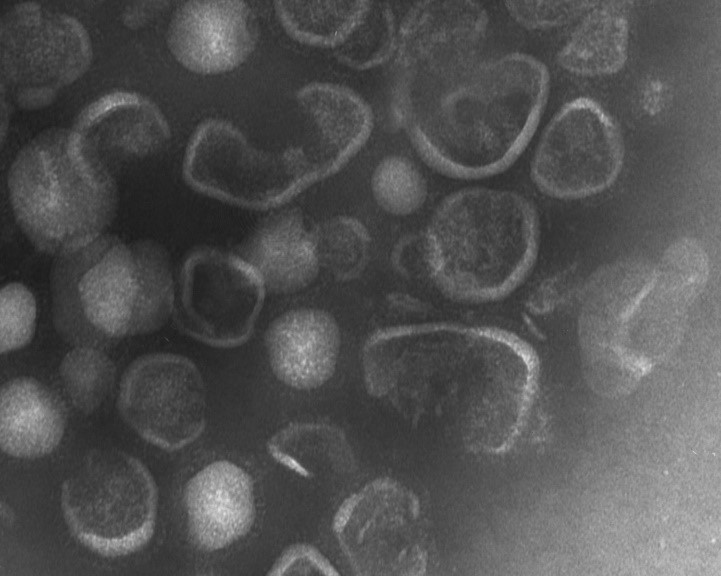
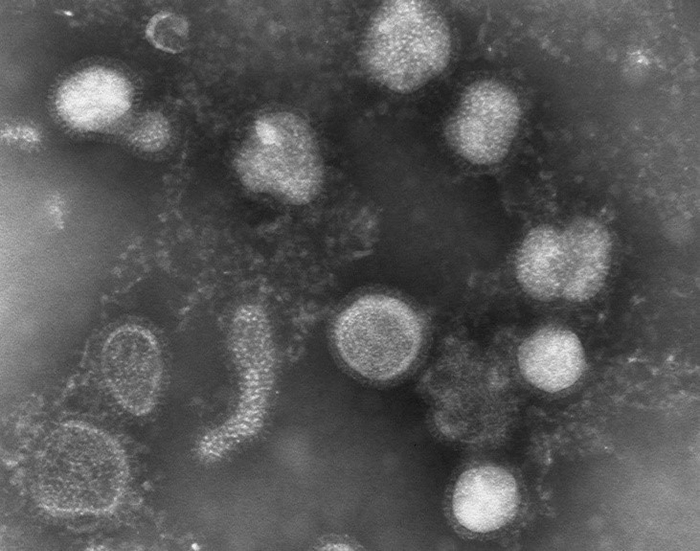

世界初:新型コロナウイルスをオゾン分子水で強力に不活化。 飛沫・浮遊ウイルスにも効果大
モルトロンオゾン分子水で駅や繁華街を広域に強力浄化。 競技場や医療施設等ヒトの居る空間のマイクロ飛沫浄化に有効 (株式会社アースシンク55が開発したモルトロンオゾン分子水について 認定特定非営利活動法人バイオメディカルサイエンス研究会から 以下の発表をいたしました)
認定NPO法人バイオメディカルサイエンス研究会は、NPO法人NBCR対策推進機構の依頼により殺菌性能評価試験を行い、以下の結果を得ました。本リリースは、オゾン分子水の安全性、安定性、有効性が、感染症対策に広く適応できる可能性を把握したという報告となります。
人体に害があるとされて日本国内では噴霧や洗浄ができなかった消毒薬。市街地や駅の除染は一切行えませんでした。WHOやCDC、厚生労働省のコメントでは、ヒトのいる空間のマイクロ飛沫等の殺菌技術は存在しない。とされてきました。LED-UVランプは、紫外線光源から数センチにしか強い効果は届きません。
モルトロンオゾン分子水は、新型コロナウイルスはもとより、高病原性鳥インフルエンザウイルスを0秒で完全に不活化。世の中の病原体の中で最も殺菌が難しいとされる炭疽菌芽胞(生物テロ兵器)までを数秒で完全に滅菌することが実証されました。さらにVXガスやマスタードガス(化学テロ兵器)も1秒以内に完全分解という、あらゆる薬剤でできなかった圧倒的な無害化効果/酸化作用を発揮する機能水です。
強力でありながら、環境への残留性は一切なく、ヒトにも安全で無害に使用が可能です。
○ヒトコロナウイルスは、モルトロンオゾン分子水により数秒間で、不活化ができることが実証されました。
○実大空間中においてモルトロンオゾン分子水は、浮遊する乳酸菌を数秒間で死滅させることを実証しました。またその際の環境オゾンガス濃度は0.1ppmを越えることなく安全に制御できることが確認できました。新型コロナウイルスの感染拡大に対して、空間に浮遊するウイルスを不活化する技術はクラスター等を抑制するために非常に重要であると考えます。
(注1)ヒトコロナウイルスは、新型コロナウイルス(COVID-19)と極めて近いRNAを有するウイルスです。
(注2)消毒薬の細菌・ウイルスの対する殺菌効果の係数を用い、本実験では乳酸菌の殺菌効果を把握することで新型コロナウイルスの不活化効果を推定しました。
殺菌システムに求められる3つの要素
安全性
・オゾン水は「薬剤」ではなく、これまでも水道水の浄化技術として使用され高い効果が認められてきました。
・オゾンガスは0.1ppm、1日8時間、週40時間程度の平均暴露濃度以下であればほぼ全ての労働者に健康上の悪影響がみられないとされています(日本産業衛生学会基準/提案年度1963年)。モルトロンオゾン分子水の実大空間実験により、この基準を超えずに使用できることが確認されました。
安定性
・旧来、大気圧での濃度半減期が1分から数分とされてきた溶存オゾン濃度がモルトロンオゾン分子水では約1500倍程度安定化されており、高濃度で吸引すると人体に影響があるとされるオゾンガスの脱気が極めて少なく安全に使用ができます。
・通常のオゾン水では配管10~20mの短距離で濃度を維持することができませんでしたがモルトロンオゾン分子水では200m配管中を送水して85%以上の濃度を維持することができます。
・通常のオゾン水では、ノズルで100ミクロンの微細噴霧をした場合、水中のオゾンはガスとして空気中に全て散逸し、溶存オゾン濃度を維持することはできませんでした。モルトロンオゾン分子水は超微細噴霧器(5ミクロンの水粒で噴霧)で噴霧しても濃度を維持し、空間の除菌ができることが判りました。(1,000ミクロン=1ミリ)
有効性
・モルトロンオゾン分子水は、通常のオゾン水に比べ溶解度が高いことで、高濃度のオゾンを水粒中に保持することができ、
殺菌効果をあげることができました。
認定特定非営利活動法人バイオメディカルサイエンス研究会(BMSA)
〒104-0021 東京都品川区上大崎2-20-8
TEL : 03-5740-6181
URL : http://www.npo-bmsa.org

開発機関
NPO法人NBCR対策推進機構(Institute for Biological Chemical and Radiological Defense)
〒111-0053 東京都台東区浅草橋2-7-9
理事長: 井上 忠雄
TEL : 03-5829-6187
FAX : 03-5829-6197
E-mail: info@nbcr-taisaku.com
ロゴ : https://www.atpress.ne.jp/releases/245850/img_245850_12.jpg
開発機関
株式会社アースシンク55(モルトロンオゾン分子水装置製造メーカー)
〒157-0062 東京都世田谷区南烏山2-30-14-101
代表取締役: 松村 栄治
携帯 : 080-5956-2941
URL : http://www.earththink55.co.jp
E-mail : moltron55@gmail.com


モルトロンオゾン分子水の構造(予想図)。オゾンが気泡でなくオゾン分子のまま水中に超高密度に溶存している。オゾンは水に難溶解性であり通常オゾン水では気泡として溶存していたが、極微のオゾンガス分子を溶存させることのできるモルトロンオゾン分子水では、微細噴霧した水粒中にオゾンが溶けており、ウイルスの不活化に効果を発揮することができます。